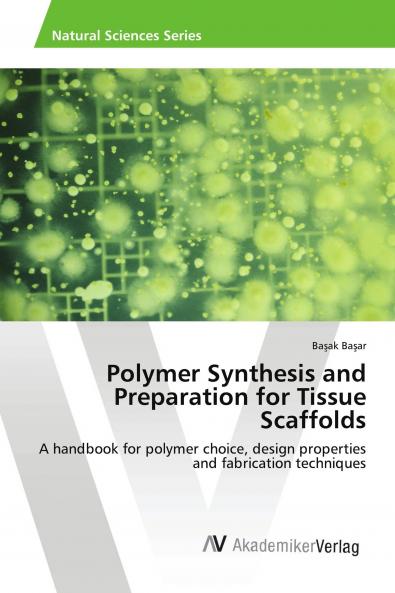
Polymer Synthesis and Preparation for Tissue Scaffolds

English
Paperback
₹5772
(All inclusive*)
Delivery Options
Please enter pincode to check delivery time.
*COD & Shipping Charges may apply on certain items.
Review final details at checkout.
Looking to place a bulk order? SUBMIT DETAILS
Delivery Options
Please enter pincode to check delivery time.
*COD & Shipping Charges may apply on certain items.
Review final details at checkout.
About The Book
Description
Author
The tissue engineering concept is based on cells typically taken from a patient multiplied in number and seeded on a scaffold. The main function of a tissue engineered-scaffold has to fulfill mimicking the ECM characteristics and properties in native tissues. Briefly the scaffold is a 3D substrate and serves as a template for tissue regeneration. Model scaffolds should have some features to accomplish the fundamental demands of a target tissue namely having an appropriate surface chemistry and microstructure to ease the cellular attachment proliferation differentiation and obtaining an acceptable mechanical strength biodegradation rate and biocompatibility. This book aims to review most of the critically valuable issues related to scaffold design polymer choice and general requirements for ideal scaffolds scaffold fabrication techniques and polymer synthesis methods. Surface characteristics of commonly used polymers (PLA PGA and PLGA) are summarized. Furthermore scaffold fabrication techniques are deeply analyzed; benefits and obstacles of the techniques are compared. Polymers for tissue-engineered scaffolds are discussed with respective of synthesis techniques suitability compatibility to the scaffold''s architecture such as pore size and size distributions. Effects of the architecture on the cells'' growth are also examined.
Details
ISBN 13
9783639631005
Publication Date
-02-06-2014
Pages
-92
Weight
-137 grams
Dimensions
-150x220x5.33 mm